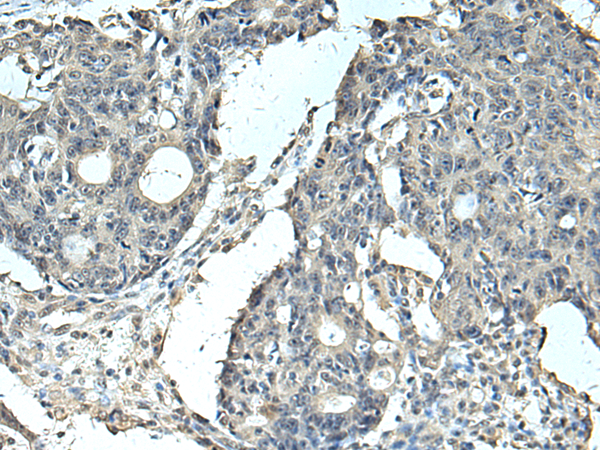

|
Background: |
Involved in the maintenance of mitochondrial membrane potential in pancreatic ductal adenocarcinoma (PDAC) cells. Promotes pancreatic ductal adenocarcinoma (PDAC) cell growth. May play a role as a nucleotide-sugar transporter. |
|
Applications: |
ELISA, IHC |
|
Name of antibody: |
SLC35F6 |
|
Immunogen: |
Fusion protein of human SLC35F6 |
|
Full name: |
solute carrier family 35 member F6 |
|
Synonyms: |
ANT2BP; TANGO9; C2orf18 |
|
SwissProt: |
Q8N357 |
|
ELISA Recommended dilution: |
5000-10000 |
|
IHC positive control: |
Human colorectal cancer and Human tonsil |
|
IHC Recommend dilution: |
100-300 |

購物車
購物車 幫助
幫助
 021-54845833/15800441009
021-54845833/15800441009
